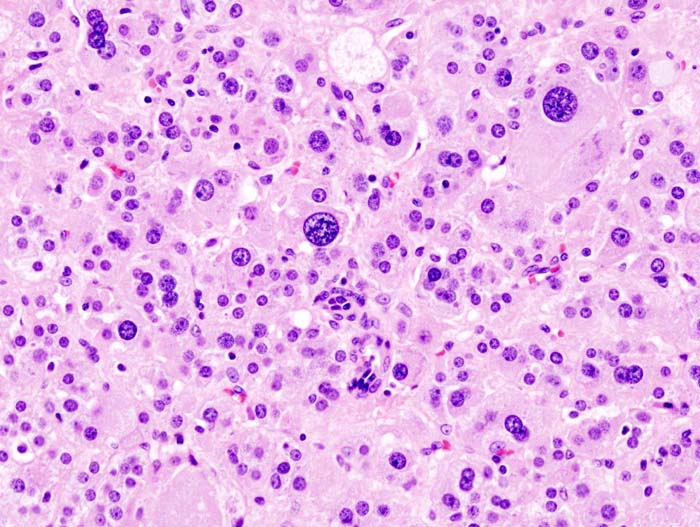

부신피질 및 수질 종양
이론과 하이라이트 히스토리를 확인 할 수 있어요.
부신피질 및 수질 종양
1. 부신피질샘종, 암종 (adrenocortical adenoma/carcinoma)
• 대부분의 부신피질 종양은 원발성임
• 일부는 germline TP53 변이로 인한 Li-Fraumeni syndrome, 또는 IGF-2의 epigenetic imprinting의 오류로 인한 Beckwith-Wiedemann syndrome의 형태로 나타남
(1) 부신피질샘종 (adrenocortical adenoma)
• 대부분 비기능성이며 우연히 발견됨
• 일부 기능성 종양은 쿠싱증후군 또는 원발성 알도스테론증을 유발
• 육안적으로는 주변 조직과의 경계가 명학하며 피막으로 둘러싸인 2.5cm 지름의 결절이 관찰됨; 높은 지방 함유량으로 인해 노란색을 뜀
• 조직학적으로는 정상 부신피질과 유사한 세포로 구성됨; 이형성, 괴사, 고유사분열 등은 없으며 mitotic index인 Ki-67은 5% 미만임
(2) 부신피질암종 (adrenocortical carcinoma)
• 드문 종양이지만 침습적이며 예후가 불량함
• 종종 기능성이며 남성화가 주된 증상
• 지름 20cm에 달하는 거대 병변으로, 정상 부신 구조를 파괴함
• 육안적으로 관찰시 병변은 불균일하며, 정상 조직과의 경계가 불명확하고 괴사, 출혈, 낭성변화 등이 동반됨
• 조직학적으로 현저한 이형성(atypia), 비정상적인 유사분열, 거대세포 또는 방추세포 등이 관찰됨
• 혈관, 정맥, 림프절, 주변 장기를 잘 침범하며 폐 또는 간으로의 혈행성 전이가 흔함

2. 부신골수지방종 (adrenal myelolipoma)
이론부터 문제까지, 알렌의 서재를 100% 활용하세요
※ 로그인 후 이용권 구매 시 전체 이용 가능합니다.
6,000개 이상의 문제와 연결되는 이론으로 개념과 적용을 한 번에
실제 국시와 동일한 CBT 환경으로 실전 감각 완성
틀린 문제를 매일 자동으로 챙겨주는 ‘오늘의 문제’
메모·암기카드·노트로 만드는 나만의 복습노트
커뮤니티 Q&A
위 이론과 관련된 게시글이에요.
이해가 안 되거나 궁금한 점이 있다면 커뮤니티에 질문해 보세요!
로그인